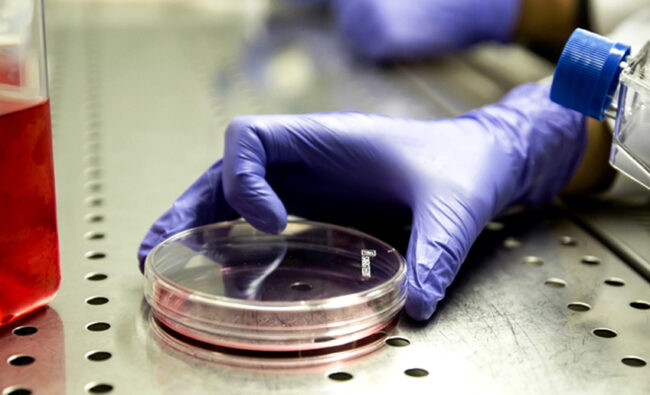
Pillole2

Why file a patent?
The Patent is the legal instrument that allows those who have created an invention to obtain the right to produce and market the invention exclusively in the State in which it was requested (art. 1 L.I.). This protection represents the cornerstone of innovation for private individuals and large companies for this reason, the use of…